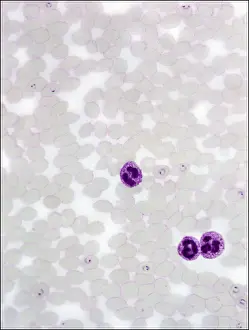

Protista Collection
"Exploring the Intricate World of Protista: From Pressed Seaweed Specimens to Microscopic Wonders" In this captivating journey through the diverse realm of protista
All Professionally Made to Order for Quick Shipping
"Exploring the Intricate World of Protista: From Pressed Seaweed Specimens to Microscopic Wonders" In this captivating journey through the diverse realm of protista, we encounter a fascinating array of organisms. The pressed seaweed specimens C016 / 6127 reveal intricate patterns and textures that hint at the hidden beauty within. Diatoms, as seen under a scanning electron microscope (SEM), showcase their mesmerizing geometric shapes and delicate structures. Dictyota dichotoma, a brown algae commonly known as mermaid's fan, unveils its elegant fronds swaying in underwater currents. Illustrations depicting hummingbirds from the Trochilidae family remind us of the interconnectedness between these avian wonders and protists. These tiny creatures rely on nectar produced by flowering plants like Fucus bulbosus, a type of kelp found along coastal regions. Another diatom specimen captured under SEM reveals its intricate details, highlighting nature's artistry at microscopic scales. Fucus radiatus, another species of kelp with branching thalli resembling miniature forests beneath the waves, showcases its resilience in harsh marine environments. Moving beyond seaweeds and birds, illustrations introduce us to liverworts from the Hepaticae family - primitive land-dwelling plants that share an ancient lineage with protists. Their unique reproductive strategies have allowed them to thrive for millions of years. However, not all protists are benign or beneficial; some can cause harm. Plasmodium sp. , a malarial parasite transmitted by mosquitoes, serves as a stark reminder of how these microorganisms can impact human health. Radiolarians belonging to Acanthophracta group astonish with their intricate skeletal structures made up of silica shells. Coelosphaeridium presents yet another marvel – calcareous alga adorned with ornate patterns reminiscent of stained glass windows. Throughout this exploration into the world of protista, diatoms emerge as prominent protagonists.